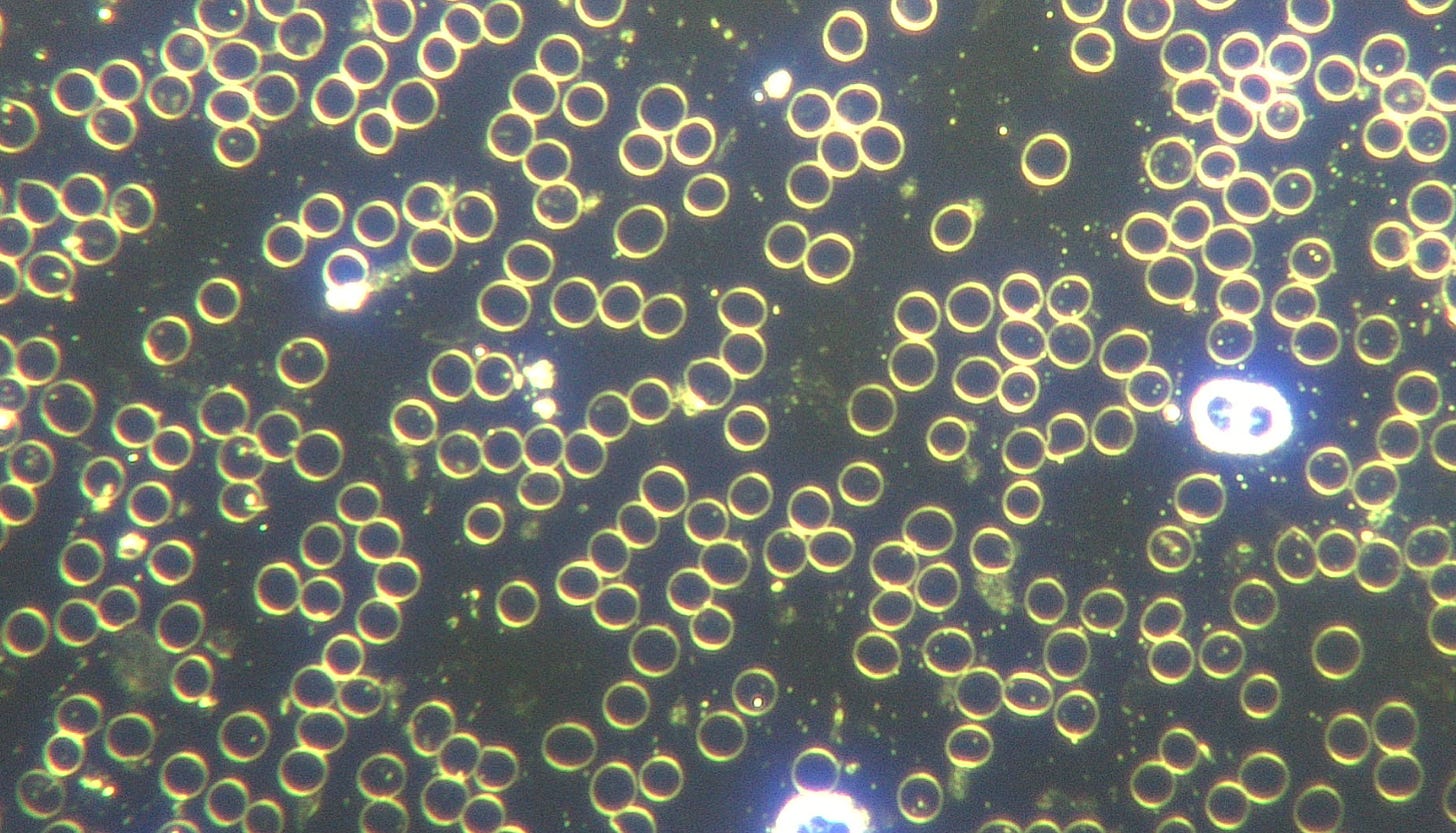

Une personne ciblée, porteuse d'implants de micropuces , a constaté une réduction de la douleur et une amélioration de sa voix après une désintoxication et un traitement
- Obtenir le lien
- X
- Autres applications
https://anamihalceamdphd.substack.com/p/targeted-individual-with-proven-microchip?
Image reproduite avec l'aimable autorisation de Richard Lighthouse, Targeted Justice.
Dans ce message, je partage des documents médicaux concernant l'un de mes patients non vaccinés contre la COVID-19 - une personne ciblée qui a été torturée par les programmes de ciblage civils secrets du gouvernement américain et de l'armée depuis 2002. (Les noms et les informations d'identification sont omis pour des raisons de confidentialité du patient).
Le patient est un citoyen de 52 ans, respectueux des lois, victime d'un accident de voiture en 2002 qui a nécessité une intervention chirurgicale pour des fractures. Lors de cette opération, plusieurs micropuces lui ont été implantées ; c'est à partir de ce moment que son calvaire a commencé. C'est un homme d'une bonté exceptionnelle, dont la sincérité et la dévotion envers Dieu m'ont profondément touché. Il implore Dieu de lui donner la force et d'intercéder dans sa souffrance. Malgré ses tourments quotidiens insoutenables, il aide son prochain du mieux qu'il peut, notamment d'autres personnes ciblées et des enfants victimes de torture par armes à micro-ondes.
Lorsqu'il s'est présenté à ma clinique, il m'a montré des photos de brûlures au micro-ondes sur son visage et son corps, qu'il a dû endurer. Il en souffre quotidiennement, ayant souvent l'impression d'être électrocuté de l'intérieur.
Il est constamment torturé par des pensées injurieuses. Sa force et son endurance me semblent surhumaines. Il a trouvé, grâce à la prière, des moyens d'ignorer ce supplice incessant dans sa tête, mais c'est un combat permanent contre la volonté.
Mon patient a subi plusieurs examens d'imagerie révélant la présence de micropuces implantées. Ces emplacements correspondaient aux zones de torture les plus sévères. Ci-dessous, vous pouvez voir une micropuce entourée :
Il y en a un autre à la base du sacrum :
Voici une dans le cerveau :
L'examen TEP cérébral haute définition montre la micropuce au même endroit :
Une autre fracture est présente au niveau de la crête iliaque droite.
Le patient a subi un examen H-SCADA complet du corps, qui a permis de localiser les émissions de fréquences provenant des implants de microprocesseurs, également détectées lors des examens radiologiques. Le rapport explique que ces émissions indiquent la présence d'un capteur ou d'un dispositif électronique, dont plusieurs sont des semi-conducteurs.
L'analyse de sang vivant que j'ai effectuée lors de son premier jour à ma clinique a révélé une nanotechnologie auto-assemblée avec un assemblage de micropuces mésogènes dans le sang :
Image : Microprocesseurs nanotechnologiques auto-assemblés et stress oxydatif du sang indiquant une récupération d’énergie. Grossissement : 100x. © Dr Ana Mihalcea
Image : microprocesseurs auto-assemblés, zone de construction visible. Grossissement : 400x. © Dr Ana Mihalcea
Image : micropuce mésogène auto-assemblée par nanotechnologie. Grossissement : 400x. © Dr Ana Mihalcea
Image : filament nanotechnologique auto-assemblé, microprocesseurs et formation étendue de rouleaux de sang. Grossissement : 100x. © Dr Ana Mihalcea
Formation importante de rouleaux observée autour de la technologie :
Image : filament nanotechnologique auto-assemblé et formation étendue de rouleaux sanguins. Grossissement : 100x. © Dr Ana Mihalcea
Le patient a subi 4 jours de thérapie intraveineuse intensive, comprenant une chélation IV à l'EDTA avec de la vitamine C, du glutathion, du Plaquex, du bleu de méthylène, du DMSO et plusieurs autres composés.
Il utilisait quotidiennement l'appareil Tezla Plasma, et je lui avais indiqué de placer les ampoules directement au-dessus des micropuces implantées. Après la première séance, non seulement il se sentait mieux, mais il a immédiatement remarqué que les micropuces vibraient fortement, comme si elles bougeaient.
Au cours des quatre jours de traitement, le patient a constaté une diminution significative de l'intensité et de la gravité de ses sifflements vocaux. Ce résultat est comparable à celui d'autres patients atteints du syndrome de la voix étranglée qui ont consulté dans ma clinique. Les symptômes ne disparaissent pas complètement, mais de nombreux patients constatent une amélioration.
Il signale également une diminution significative de la gravité des tortures et des attaques au micro-ondes, avec beaucoup moins de douleur et une intensité, une gravité et une fréquence considérablement réduites.
Son analyse sanguine après 4 jours de traitement a montré une nette amélioration. Il est impossible d'obtenir un échantillon sanguin parfait et des anomalies peuvent toujours être observées sur la lame. Je recherche désormais une quantification globale des micropuces et filaments polymères, des quantités totales de microrobots et de la qualité cellulaire comme indicateur d'amélioration, en parallèle avec d'autres résultats objectifs, tels que l'amélioration des marqueurs inflammatoires en laboratoire, de la fonction rénale, l'augmentation de la tension cérébrale lors des tests du système nerveux autonome et de l'EEG fonctionnel, ainsi que l'amélioration des symptômes cliniques.
Analyse sanguine en champ sombre (jour 4 du traitement) : amélioration de la qualité du sang et réduction significative des anomalies microtechnologiques. Grossissement : 200x. © Dr Ana Mihalcea
Je vérifie systématiquement la résistance de la membrane cellulaire et la présence de reflets dorés à l'intérieur de la cellule, signes de restauration de sa capacité électromagnétique, ainsi que la dissolution des rouleaux. Aucun filament polymère ni microprocesseur n'a été observé.
Analyse sanguine en fond noir (jour 4 du traitement) : amélioration des paramètres sanguins. Grossissement : 2000x. © Dr Ana Mihalcea
___________________________________________________________________________
Mariano du club Tzla m'a envoyé cette image microscopique d'une micropuce extraite de la peau après utilisation de la machine Tzla.
Image : Puce électronique d’une personne non vaccinée contre la COVID-19, sortie avec l’appareil de traitement au plasma. Image prise avec le mode macro de l’appareil photo d’un smartphone fixé au microscope. Grossissement : 120x.
Lorsque nous utilisons les machines dans mon bureau, aucun ordinateur ni appareil technologique des pièces voisines ne fonctionne, car le champ de guérison est très puissant. Nous poursuivons nos recherches sur la méthodologie et l'innocuité des approches combinées utilisant la machine pour désactiver les nanotechnologies auto-assemblées et diverses thérapies médicales combinées. Toute amélioration des symptômes de cette terrible torture est un soulagement bienvenu.
J'ai évoqué la machine à force vitale plasmatique dans mes entretiens avec Jeff Berwick.
_______________________________________________________
Si vous pensez un seul instant que c'est impossible – que des médecins criminels à travers le pays travaillent pour les services de renseignement militaire afin d'implanter des micropuces à des êtres humains – détrompez-vous, car il existe des preuves.
Nos forces armées et nos services de renseignement comptent des éléments corrompus, de véritables technocrates satanistes, déterminés à anéantir l'humanité. Ils considèrent l'humanité comme un ensemble d'animaux sans âme, faciles à pirater, mais, hélas, ils sont eux-mêmes plus abjects que n'importe quel animal.
Des lâches qui torturent des civils innocents et des enfants jusqu'au suicide ; aucune créature vivante n'est tombée plus bas qu'eux. Tapis dans l'ombre tels des démons pervers avides de pouvoir, d'argent et de contrôle, ils nous montrent ce que nous ne voulons jamais devenir : des psychopathes amoraux et sans compassion. Ils peuvent se dissimuler dans l'ombre criminelle de programmes gouvernementaux secrets et d'un système judiciaire corrompu, mais ils ne pourront échapper au karma.
Lorsque je découvre cette injustice horrible qui me fait souvent pleurer en voyant la personne en face de moi, je réalise à quel point l'avidité toxique, la soif de pouvoir, l'idée arrogante qu'un être humain est plus spécial qu'un autre, le concept d'être « choisi » et en droit de faire la guerre aux autres, le manque total d'intégrité et d'honneur menant à la corruption absolue, l'addiction à la destruction et à la souillure de la vie – ce sont des attitudes tellement néfastes que nous devons faire tout notre possible pour nous guérir et nous débarrasser de toute trace de tels états émotionnels.
Si l'argent et le pouvoir peuvent pousser certains à agir ainsi envers leurs semblables, à renoncer à tout ce qui constitue le bien commun, c'est bien le symptôme d'une société en proie à un effondrement de conscience. Ce n'est qu'à titre individuel que nous pouvons emprunter le chemin difficile du pardon envers soi-même vers la sagesse, du changement vers la maturité, du dévouement égocentrique à une appréciation compatissante du caractère sacré de toute vie.
Je vous le dis, aucun animal sur cette bonne vieille terre n'est aussi dégradé que les technocrates satanistes de notre complexe militaro-industriel et pharmaceutique. La nature ne s'abaisse pas à un tel niveau, et aucune super-intelligence artificielle ne changera ce fait.
Ces crimes contre l'humanité ne témoignent pas d'une civilisation avancée, peu m'importe que vous puissiez envoyer des fusées sur Mars.
Nous sommes tous des êtres spirituels divins, dignes d'amour, d'appréciation et d'attention.
_______________________________________________________
Si vous souhaitez aider vos semblables, des civils innocents que l'on implante avec des micropuces lors d'interventions médicales de routine et qui sont torturés par le gouvernement, l'armée et les services de renseignement américains, veuillez apporter votre soutien et faire un don à
TARGETED JUSTICE ET AVOCATE ANA TOLEDO . Vous pouvez découvrir leur courageux travail dans ce documentaire récemment sorti :
Il est important de soutenir leur cause, car c'est ce que les technocrates veulent faire à l'HUMANITÉ TOUT ENTIÈRE, comme l'indique le déploiement des armes de destruction massive nanotechnologiques liées à la COVID-19.
Pour plus d'informations :
*****************
https://etouffoir.blogspot.com/2025/08/individus-cibles-transcription.html
Interview de l'avocate Ana Toledo
https://etouffoir.blogspot.com/2025/08/personnes-ciblees-une-fois-que-vous.html
savoir pour pouvoir se protéger
https://etouffoir.blogspot.com/2025/11/un-nouveau-documentaire-incontournable.html
- Obtenir le lien
- X
- Autres applications

J'ai fait face pendant plusieurs semaines au phénomène de "la voix étranglée".Ma voix avait perdu sa densité. Elle était poussive et aigue comme un brouillon de ma voix habituelle et difficilement audible pour mes interlocuteurs. Elle me faisait penser à celle de RFK. Cela s'est terminé tout d'un coup, sans que je fasse quoi que ce soit de particulier. Jusqu'à la lecture de cet article, je ne savais pas que d'autres personnes avaient subi ce phénomène. Je suis ciblée par énergie dirigée depuis très longtemps.
RépondreSupprimerEn bas à gauche de l'illustration de TARGETED JUSTICE on trouve :
RépondreSupprimer"placed on the watch list as an uninvestigated subject" et qui signifie
" mis sur une liste de surveillance en tant qu'individu sur lequel IL NE FAUT PAS FAIRE D'ENQUÊTE"
C'est pour cette raison que pour ESSAYER de se défendre les individus ciblés doivent le faire par des sujets annexes en évitant le sujet principal des attaques par énergie dirigée qui ne sont encadrées par aucune loi.